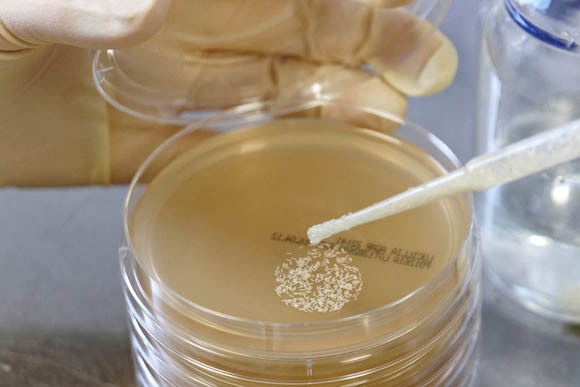
A pipette is used to set the eggs on the culture medium in a Petri dish

THE LARVAE USED IN THIS PROCESS ARE PRODUCED IN NORTHERN GERMANY
The breeders manage the entire life cycle of these two-winged insects, from fly to egg to larvae. And they find these insects very likable. The basic requirements for maggot therapy include the special culture media from Merck KGaA, Darmstadt, Germany that are needed to breed the larvae.
If larvae are swarming in a wound, the process of debridement — the removal of dead, damaged, or infected tissue to promote healing — is accelerated. This kind of wound treatment by larvae increases the patient’s chances of survival. That’s why the French surgeon Dominique-Jean Larrey (1766–1842) was delighted when he saw larvae swarming in the wounds of injured soldiers in a battlefield hospital in Syria. The soldiers themselves, however, wanted these apparent messengers of doom to be removed at any price. But Larrey had observed that these larvae accelerated the healing of wounds, thus helping nature to do its work. He had also observed that these larvae only attacked dead tissue and “always spared living flesh.”